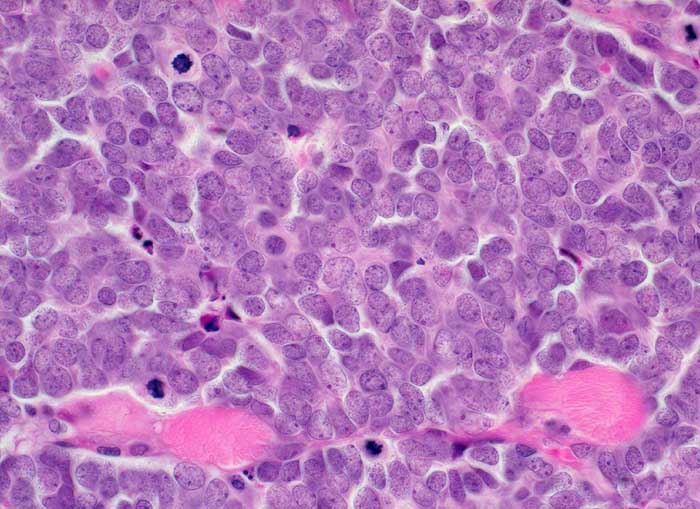

PathoPic – image database / PathoPic ID 5484 - Merkel Zell Karzinom
de
Diagnose
Merkel Zell Karzinom
Diagnose Gruppe
maligner Tumor
Topographie
Haut, Lid
Topographie Gruppe
Haut
Beschreibung
Solides sehr monomorphes Tumorzellinfiltrat. Die Tumorzellen haben praktisch kein Zytoplasma. Das Chromatin ist fein granuliert. Die Kerne enthalten feine Nukleolen. Zahlreiche Mitosen. Der Tumor infiltriert die Skelettmuskulatur.
Zusatzbefund
Immunhistochemie: CK20 und Synaptophysin positiv. Melanommarker, CD20, CD45, TTF1 negativ.
Klinik
Tumor am Unterlid
Bilder Typ
Histologie
Vergrösserung
400
Alter
80
Geschlecht
männlich
Datum
Ersteintrag: 06.10.2002
Update: 11.02.2003